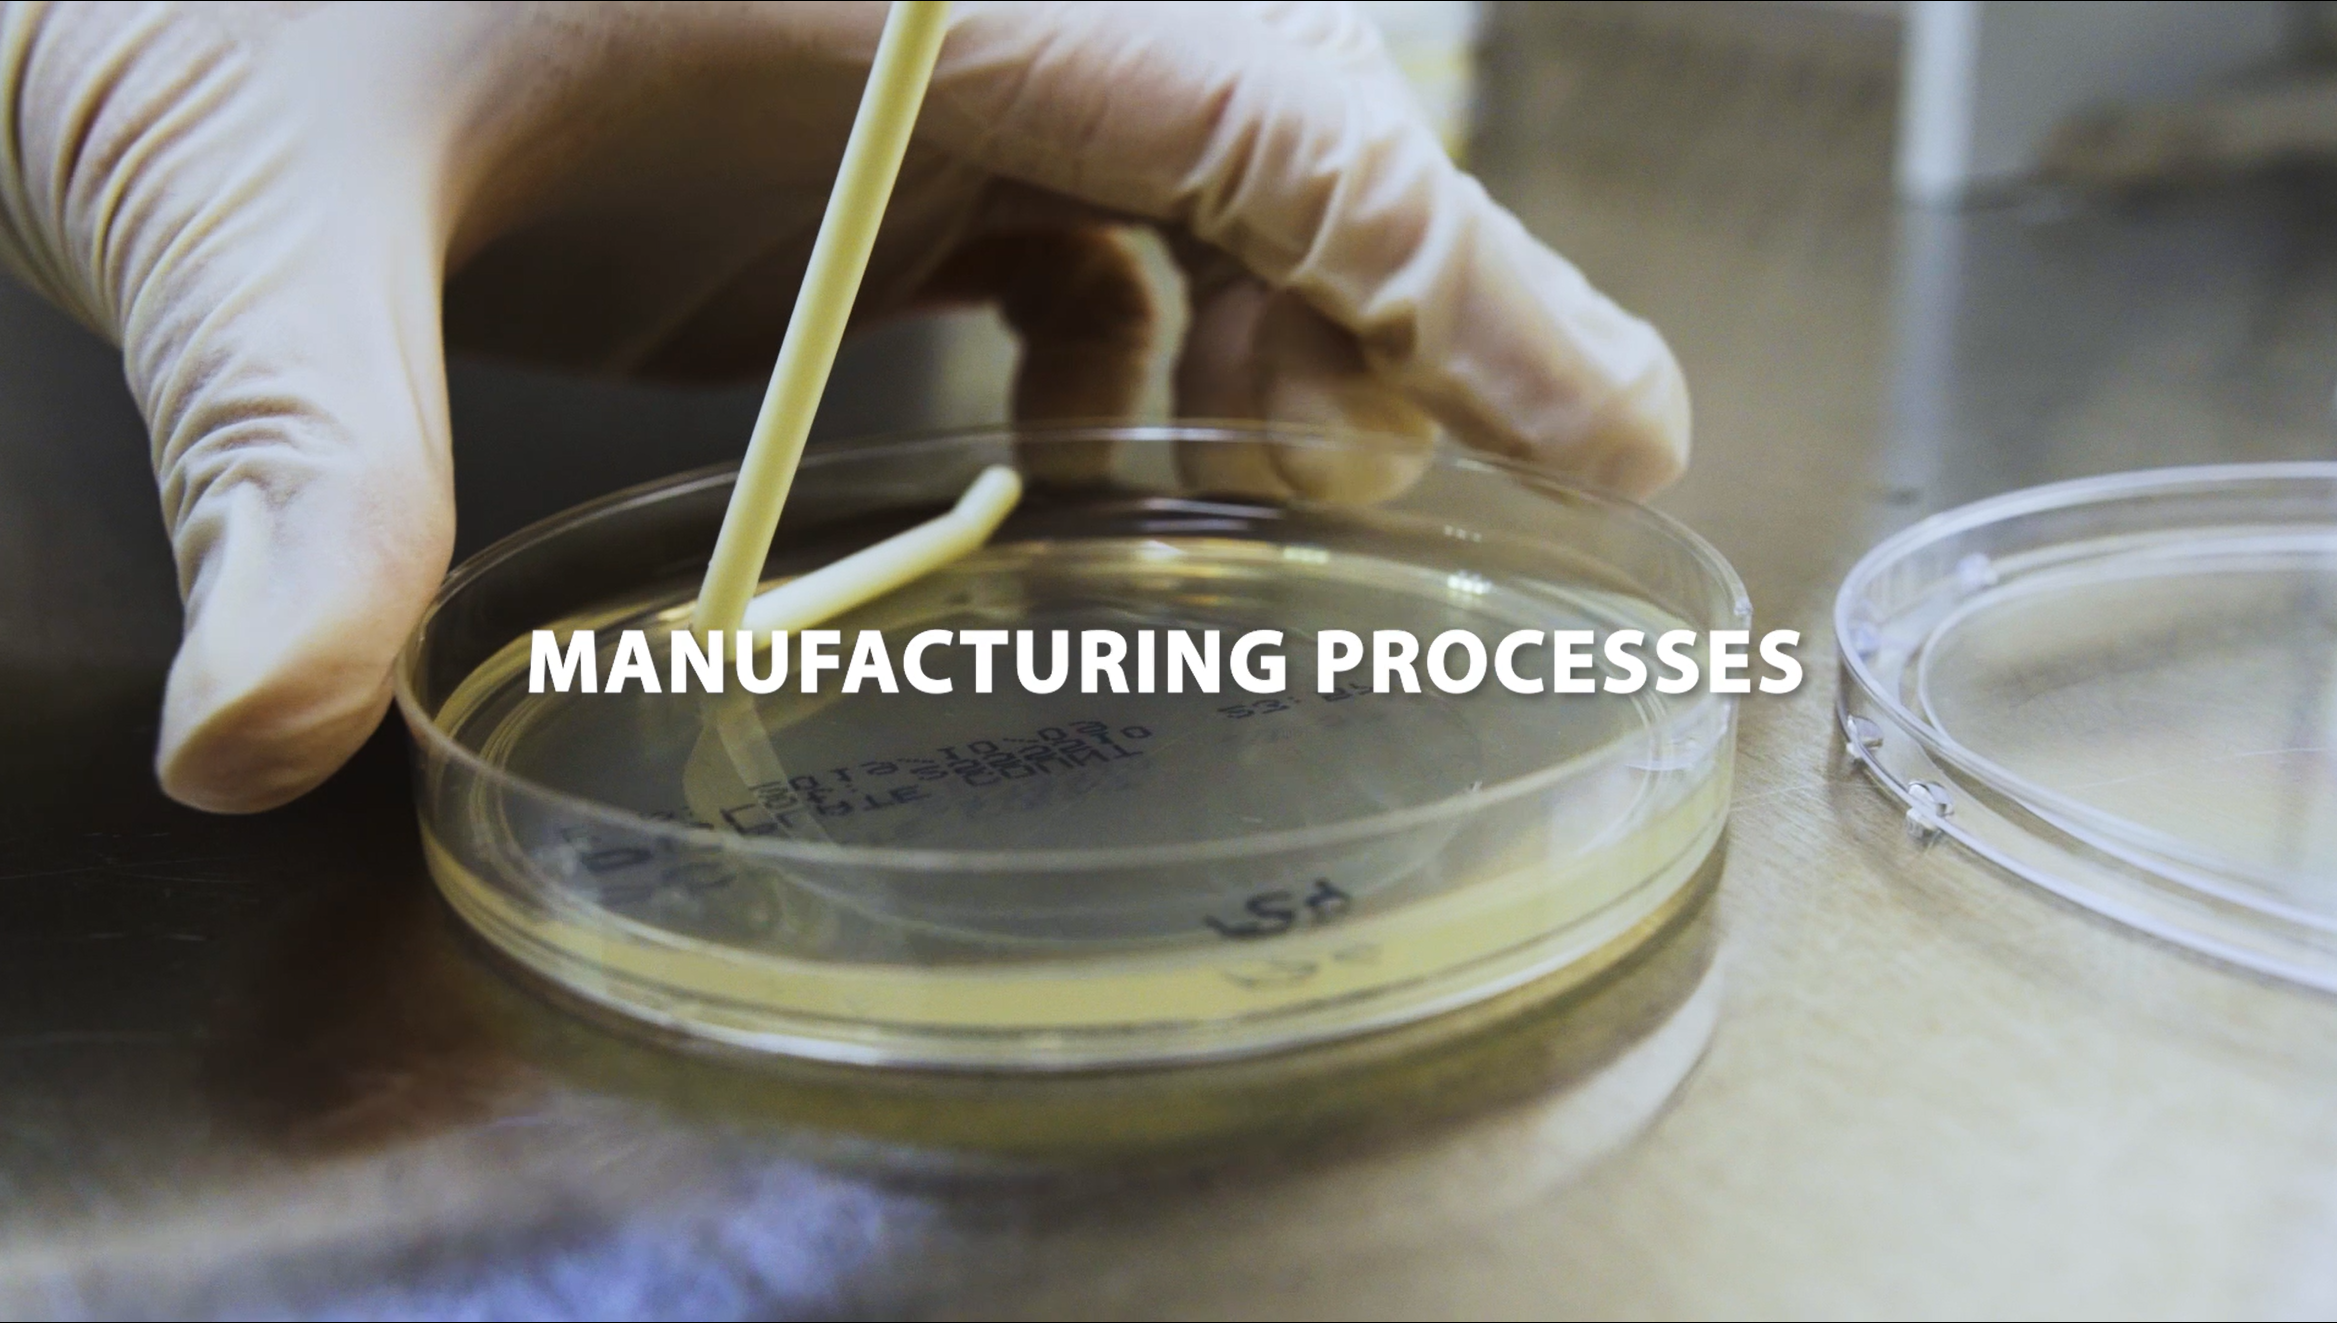

Quality
The quality and safety of our products is our top priority.
Fapomed is certified according to ISO 13485:2016, demonstrating a robust Quality Management System specifically designed for the development, manufacture, and distribution of medical devices.
All medical devices are compliant with the Medical Device Regulation (MDR) (EU) 2017/745, ensuring the highest levels of safety, performance, and regulatory conformity for the prevention of nosocomial infections. In addition, Fapomed’s products meet the requirements of EN 13795, confirming their suitability for use in critical healthcare environments.
These standards are supported by a highly qualified and experienced team, whose expertise and commitment ensure consistent quality and safety from raw-material to final product.
Our Laboratory
Bio & Physics Lab was implemented within Fapomed’s facilities to meet the demands of the competitive market in which the company operates.
The laboratory is equipped with appropriate infrastructure and capacity to perform physical and microbiological testing, including climate-controlled environments and facilities that comply with international standards.
Bio & Physics Lab conducts tests related to raw materials used in medical devices, qualification of production processes, ultrasonic sealing of materials and packaging.
Bio & Physics Lab is committed to achieving the highest levels of accuracy and the lowest possible uncertainties associated with experimental procedures. As such, physical and microbiological testing plays a crucial role in fulfilling its core mission: release safe, reliable and high quality products.
Laboratory Testing Portfolio
At our Bio & Physics Lab, we offer a comprehensive portfolio of laboratory tests across a wide range of segments, including in particular:
EN 13795:
- EN ISO 811 | Resistance to liquid penetration
- EN 29073-3 | Tensile strength and elongation – dry and wetIST 80.6-92 | Alcohol repellency rating
EN 29073-1 | Mass per unit area
ISO 9073-11 | Run-off
EN 868-5, Annex D & C | Seal strength and seal width – dry and wet
EN ISO 11607-1, Annex B and based on ASTM F1929 | Seal integrity
Packaging validation testing: OQ, PQ, and results analysis, carried out based on the assessment of each specific study.
We ensure efficient and reliable responses, supported by the experience, quality, and rigor acquired over 40 years of history.

Controlled and Safe Manufacturing Environment
Fapomed operates an 800 m² clean room, classified as ISO 7.
It is equipped with HEPA filtration systems with 99.95% efficiency, ensuring effective removal of particles up to 5 µm.
This controlled environment guarantees high levels of safety, quality, and process reliability in medical device manufacturing.

Innovation as a Driver of Evolution
Innovation is a core pillar of Fapomed’s evolution. It drives our strategy and shapes our future.
Our commitment to innovation is reflected in concrete achievements.
One of them is the patent of our ultrasonic sealing technology, a milestone that reinforces our leadership in performance and reliability.
The circular economy project for hospital waste, redefining how single-use medical products are recovered, treated, and reintroduced into the value chain is one of the projects currently in our pipeline.
We develop new products designed to minimise waste from the beginning of it's lifecyle, along with the projects R&D in sustainable raw materials, and continuous rational use of resources.
Innovation is not an ambition, but a result from the continuous projecting of the long-term value creation in Fapomed.
